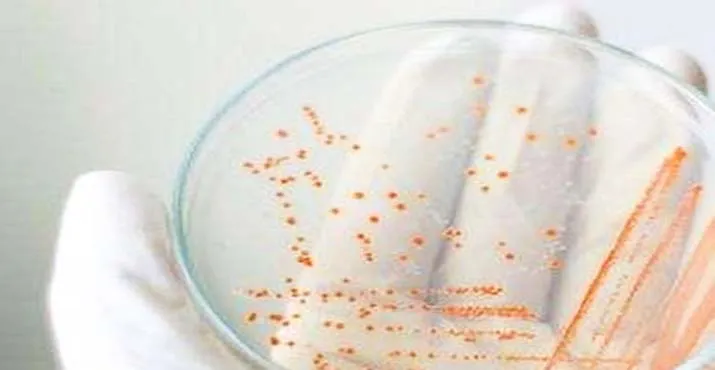

ZONASULTRA. COM – Sejak kecil kebanyakan dari kita, mungkin diajari untuk saling berbagi membantu sesama. Mulai dari mainan, peralatan, hingga uang semua bisa kita bagikan atau pinjamkan untuk membantu orang lain, dan menurut studi kebiasaan ini bisa memiliki dampak positif untuk kesehatan jiwa.
Namun demikian, ada beberapa barang pribadi yang dianjurkan sebaiknya tidak dipinjam-pinjamkan yaitu barang kebersihan. Alasannya karena hal tersebut bisa berkaitan dengan risiko kesehatan.
Dikutip dari berbagai sumber, berikut 5 barang yang sebaiknya tidak dipinjam-pinjamkan:
1. Handuk
Saling meminjam handuk bahkan meski baru dipakai sebentar saja dapat berisiko menularkan bakteri dari satu orang ke orang lain. Bakteri seperti Staphylococcus yang sering menyebabkan masalah infeksi, contohnya dapat hidup di handuk hingga berbulan-bulan.
Oleh karena itu, kepada anggota keluarga sekalipun, sangat tidak dianjurkan untuk berbagi handuk.
2. Sabun Batang
Meski sabun bila dipikirkan sekilas harusnya bersih, namun pada kenyataannya ia masih bisa menyimpan berbagai macam hal merugikan seperti bakteri dan fungi. Studi pada tahun 2006 membuktikan pada klinik gigi sabun batang menjadi sumber infeksi berulang.
“Kemungkinan bisa karena sabun batang ini tidak kering sepenuhnya di antara pemakaian terutama bagian bawahnya. Berujung pada akumulasi bakteri, fungi, dan ragi yang dapat berpindah dari orang ke orang,” ujar ahli kulit Neal Schultz.
3. Pisau Cukur
Saling meminjam pisau cukur bisa menularkan penyakit seperti kutil, folikulitis, dan kaki atlet. Alasannya karena meski pisau tampak bersih dan tidak menyebabkan luka yang berdarah, infeksi tetap dapat terjadi karena saat mencukur seseorang bisa alami luka mikro di permukaan kulit.
Karena lukanya kecil, ia tidak terlihat oleh mata telanjang. Namun cukup besar untuk menjadi infeksi oleh patogen.
4. Sikat Gigi
Bagi kebanyakan orang, berbagi sikat gigi jelas bisa jadi sesuatu hal yang menjijikkan. Namun demikian faktanya hal tersebut masih terjadi terutama di antara pasangan seperti yang ditemukan oleh survei UkBathrooms.com. Sekitar 56 persen pasangan yang disurvei mengaku sudah satu tahun atau lebih saling berbagi sikat gigi.
Menurut American Dental Association berbagi sikat gigi ini akan meningkatkan frekuensi berpindahnya bakteri antar individu. Pada akhirnya, bila satu individu imunitasnya menurun, maka ia akan lebih mungkin terserang penyakit.
5. Deodoran
Ketika produk deodoran dipakai, ia menyentuh ketiak dan terpapar dengan kulit mati serta keringat individu. Oleh sebab itu di dalamnya, bisa terdapat bakteri-bakteri yang ketika dipinjamkan maka akan berpindah.
Terkait hal ini menurut Neal, produk deodoran yang berbentuk stik bisa lebih sedikit mentransfer bakteri dibandingkan deodoran roll-on. Alasannya karena deodoran roll-on lebih lengket membuat bakteri mudah menempel karena sifatnya yang cair. (B)
(Sumber : detik.com)
Penulis : Sitti Nurmalasari













